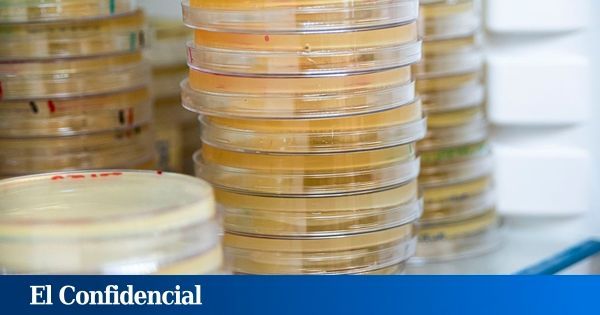
Semedlab's tweet image. ¿Las superbacterias podrían causar más muertes que el cáncer en 2050? 📢 

Así lo han advertido en el XIX Congreso Nacional de Laboratorio Clínico #LABCLIN2025 organizado por la #SEMEDLAB que ha reunido a unos 1.500 expertos 📌 

buff.ly/iqSm6sr

#semedlab результаты поиска
🎯WORKSHOP AT LABCLIN 2025 POINT OF CARE IN ACTION: The Borderless Laboratory Discover how POCT drives care in emergencies, isolations, and critical missions with real clinical cases. novabiomedical.com/es/labclin/ #LabClin2025 #SEMEDLAB #POCT

📌 La Sociedad Española de Medicina de Laboratorio #SEMEDLAB celebra la actividad “Valencia cuida tu riñón”, con el fin de acercar la actividad del Laboratorio Clínico a la ciudadanía de la Comunidad Valenciana mediante el análisis en sangre de su función renal 🩸




¡Queda oficialmente inaugurado el primer #LABCLIN2025 ‼️ El primero de #Semedlab como sociedad de medicina de laboratorio de referencia El Comité Organizador da la bienvenida a todos los asistentes 🙌🏻

Conferencia de clausura de #LabClin2025 El próximo 14 de noviembre, el Prof. Mario Plebani, una de las voces más influyentes en la Medicina de Laboratorio, ofrecerá la conferencia: “The future of laboratory medicine and future roles of laboratory professionals” #SEMEDLAB

Nueva Junta Directiva de #SEMEDLAB ‼️ Hoy se ha aprobado la nueva junta directiva de #SEMEDLAB para el periodo 2026-2028 Gracias a todos los socios por participar en la votación y felicidades al nuevo equipo que liderará esta etapa💪

¿Las superbacterias podrían causar más muertes que el cáncer en 2050? 📢 Así lo han advertido en el XIX Congreso Nacional de Laboratorio Clínico #LABCLIN2025 organizado por la #SEMEDLAB que ha reunido a unos 1.500 expertos 📌 buff.ly/iqSm6sr

Desentrañando el rol del Machine Learning en el Laboratorio Clínico. #EuroMedLab2025 #Brussels #SEMEDLAB



¡Bienvenidos a la residencia! 🥼👋 📌 Desde la Comisión de Residentes y Jóvenes Especialistas de #SEMEDLAB dan algunos #tips para que los recién llegados R1 tengan una primera toma de contacto con nuestra especialidad ‼️

📸 Imágenes de ponencias celebradas en el #EuroMedLab2025 1. Evaluating the ROMA test for Ovarian cancer 2. Colorectal cancer screening in the Netherlands 3. K+ measurement in NICU settings - risks and opportunities for improvement #SEMEDLAB #laboratorio



Roche transforma el diagnóstico por espectrometría de masas con el lanzamiento del cobas® Mass Spec #EuroMedLab2025 #Brussels #SEMEDLAB

Dan comienzo los simposios del EuroMedLab 2025. Una gran oportunidad para que los profesionales de la Medicina de Laboratorio nos mantengamos actualizados en los nuevos avances. #EuroMedLab #Brussels #SEMEDLAB

“No es autoinmune todo lo que reluce, ¿o sí?” En la I Jornada Interhospitalaria del Laboratorio Clínico hablaremos del papel de los anticuerpos en el diagnóstico de la EPID asociada a enfermedades autoinmunes. ¡Os esperamos! #SEMEDLAB #EPID @RrTechu @Semedlab…


Nace SEMEDLAB: una nueva etapa para la Medicina de Laboratorio en España. 🔬 Tres sociedades unidas para fortalecer el laboratorio clínico. Innovación, formación y excelencia nos guían hacia un futuro mejor. 🌟 #SEMEDLAB #MedicinaDeLaboratorio
📌Asamblea General Ordinaria Se ha habilitado una mesa electoral en el stand de la Sociedad #SEMEDLAB 👉Podrás emitir tu voto presencialmente entre las 10:30 y las 14:00 horas, y nuevamente entre las 15:00 y las 17:00 horas, previa identificación mediante DNI

La #SEMEDLAB y los avances en el cribado #neonatal en #España ‼️ 🎙️ Entrevista a la Dra. Yolanda González Irazábal en Radio #ElMicroscopio ¡Escúchala aquí! ▶️ buff.ly/hZXFsag
📢 ¡Amplía tu formación en Medicina de Laboratorio! 🎓🔬 #SEMEDLAB pone a tu disposición una selección de cursos especializados en #LaboratorioClínico 📚 Formación actualizada 💻 Online/Presencial 📜 Certificación 🔗 Descubre los cursos aquí: semedlab.es/cursos/
🆕 Nace la Sociedad Española de Medicina de Laboratorio #SEMEDLAB @semedlab en #LABCLIN2024 🤝Fruto de la fusión entre las tres asociaciones científicas de Medicina de Laboratorio-Laboratorio Clínico actuales en España @aebmorg @aefa_es @SEQC_ML labclin2024.es/images/site/no…

💡 ¡Hazte socio de #SEMEDLAB hoy mismo! 📋 Sólo necesitas rellenar este formulario con tus datos para estar informado sobre las últimas novedades en #Medicina de #Laboratorio 👉 buff.ly/4aPAW89
#Profesionales | Hablamos con el presidente electo de la nueva Sociedad Española de Medicina de Laboratorio #SEMEDLAB, el Dr. Antonio Buño Soto 👉 Se trata de una transformación histórica al aglutinar a todos los socios de @aebm_ml, @aefa_es y @SEQC_ML consalud.es/profesionales/…
consalud.es
Buño: “La creación de SEMEDLAB fortalece la representación de la Medicina de Laboratorio en España”
ConSalud.es entrevista al presidente electo de la nueva Sociedad Española de Medicina de Laboratorio (SEMEDLAB) que aglutinará a todos los socios de AEBM-ML, AEFA y SEQCML
¿Las superbacterias podrían causar más muertes que el cáncer en 2050? 📢 Así lo han advertido en el XIX Congreso Nacional de Laboratorio Clínico #LABCLIN2025 organizado por la #SEMEDLAB que ha reunido a unos 1.500 expertos 📌 buff.ly/iqSm6sr

📌 La Sociedad Española de Medicina de Laboratorio #SEMEDLAB celebra la actividad “Valencia cuida tu riñón”, con el fin de acercar la actividad del Laboratorio Clínico a la ciudadanía de la Comunidad Valenciana mediante el análisis en sangre de su función renal 🩸




Nueva Junta Directiva de #SEMEDLAB ‼️ Hoy se ha aprobado la nueva junta directiva de #SEMEDLAB para el periodo 2026-2028 Gracias a todos los socios por participar en la votación y felicidades al nuevo equipo que liderará esta etapa💪

📌Asamblea General Ordinaria Se ha habilitado una mesa electoral en el stand de la Sociedad #SEMEDLAB 👉Podrás emitir tu voto presencialmente entre las 10:30 y las 14:00 horas, y nuevamente entre las 15:00 y las 17:00 horas, previa identificación mediante DNI

¡Queda oficialmente inaugurado el primer #LABCLIN2025 ‼️ El primero de #Semedlab como sociedad de medicina de laboratorio de referencia El Comité Organizador da la bienvenida a todos los asistentes 🙌🏻

🎯WORKSHOP AT LABCLIN 2025 POINT OF CARE IN ACTION: The Borderless Laboratory Discover how POCT drives care in emergencies, isolations, and critical missions with real clinical cases. novabiomedical.com/es/labclin/ #LabClin2025 #SEMEDLAB #POCT

Conferencia de clausura de #LabClin2025 El próximo 14 de noviembre, el Prof. Mario Plebani, una de las voces más influyentes en la Medicina de Laboratorio, ofrecerá la conferencia: “The future of laboratory medicine and future roles of laboratory professionals” #SEMEDLAB

¡Bienvenidos a la residencia! 🥼👋 📌 Desde la Comisión de Residentes y Jóvenes Especialistas de #SEMEDLAB dan algunos #tips para que los recién llegados R1 tengan una primera toma de contacto con nuestra especialidad ‼️

📸 Imágenes de ponencias celebradas en el #EuroMedLab2025 1. Evaluating the ROMA test for Ovarian cancer 2. Colorectal cancer screening in the Netherlands 3. K+ measurement in NICU settings - risks and opportunities for improvement #SEMEDLAB #laboratorio



Desentrañando el rol del Machine Learning en el Laboratorio Clínico. #EuroMedLab2025 #Brussels #SEMEDLAB



Roche transforma el diagnóstico por espectrometría de masas con el lanzamiento del cobas® Mass Spec #EuroMedLab2025 #Brussels #SEMEDLAB

Dan comienzo los simposios del EuroMedLab 2025. Una gran oportunidad para que los profesionales de la Medicina de Laboratorio nos mantengamos actualizados en los nuevos avances. #EuroMedLab #Brussels #SEMEDLAB

“No es autoinmune todo lo que reluce, ¿o sí?” En la I Jornada Interhospitalaria del Laboratorio Clínico hablaremos del papel de los anticuerpos en el diagnóstico de la EPID asociada a enfermedades autoinmunes. ¡Os esperamos! #SEMEDLAB #EPID @RrTechu @Semedlab…


📢 ¡Amplía tu formación en Medicina de Laboratorio! 🎓🔬 #SEMEDLAB pone a tu disposición una selección de cursos especializados en #LaboratorioClínico 📚 Formación actualizada 💻 Online/Presencial 📜 Certificación 🔗 Descubre los cursos aquí: semedlab.es/cursos/
La #SEMEDLAB y los avances en el cribado #neonatal en #España ‼️ 🎙️ Entrevista a la Dra. Yolanda González Irazábal en Radio #ElMicroscopio ¡Escúchala aquí! ▶️ buff.ly/hZXFsag
💡 ¡Hazte socio de #SEMEDLAB hoy mismo! 📋 Sólo necesitas rellenar este formulario con tus datos para estar informado sobre las últimas novedades en #Medicina de #Laboratorio 👉 buff.ly/4aPAW89
Nace SEMEDLAB: una nueva etapa para la Medicina de Laboratorio en España. 🔬 Tres sociedades unidas para fortalecer el laboratorio clínico. Innovación, formación y excelencia nos guían hacia un futuro mejor. 🌟 #SEMEDLAB #MedicinaDeLaboratorio
#Profesionales | Hablamos con el presidente electo de la nueva Sociedad Española de Medicina de Laboratorio #SEMEDLAB, el Dr. Antonio Buño Soto 👉 Se trata de una transformación histórica al aglutinar a todos los socios de @aebm_ml, @aefa_es y @SEQC_ML consalud.es/profesionales/…
consalud.es
Buño: “La creación de SEMEDLAB fortalece la representación de la Medicina de Laboratorio en España”
ConSalud.es entrevista al presidente electo de la nueva Sociedad Española de Medicina de Laboratorio (SEMEDLAB) que aglutinará a todos los socios de AEBM-ML, AEFA y SEQCML
Fruto de la fusión entre tres asociaciones: AEBM-ML, AEFA y SEQCML. acortar.link/fXt8Zj #SEMEDLAB #MedicinaDeLaboratorio #Fusion #prensa #noticias
🆕 Nace la Sociedad Española de Medicina de Laboratorio #SEMEDLAB @semedlab en #LABCLIN2024 🤝Fruto de la fusión entre las tres asociaciones científicas de Medicina de Laboratorio-Laboratorio Clínico actuales en España @aebmorg @aefa_es @SEQC_ML labclin2024.es/images/site/no…

¡Queda oficialmente inaugurado el primer #LABCLIN2025 ‼️ El primero de #Semedlab como sociedad de medicina de laboratorio de referencia El Comité Organizador da la bienvenida a todos los asistentes 🙌🏻

🎯WORKSHOP AT LABCLIN 2025 POINT OF CARE IN ACTION: The Borderless Laboratory Discover how POCT drives care in emergencies, isolations, and critical missions with real clinical cases. novabiomedical.com/es/labclin/ #LabClin2025 #SEMEDLAB #POCT

Nueva Junta Directiva de #SEMEDLAB ‼️ Hoy se ha aprobado la nueva junta directiva de #SEMEDLAB para el periodo 2026-2028 Gracias a todos los socios por participar en la votación y felicidades al nuevo equipo que liderará esta etapa💪

Conferencia de clausura de #LabClin2025 El próximo 14 de noviembre, el Prof. Mario Plebani, una de las voces más influyentes en la Medicina de Laboratorio, ofrecerá la conferencia: “The future of laboratory medicine and future roles of laboratory professionals” #SEMEDLAB

¿Las superbacterias podrían causar más muertes que el cáncer en 2050? 📢 Así lo han advertido en el XIX Congreso Nacional de Laboratorio Clínico #LABCLIN2025 organizado por la #SEMEDLAB que ha reunido a unos 1.500 expertos 📌 buff.ly/iqSm6sr
📌 La Sociedad Española de Medicina de Laboratorio #SEMEDLAB celebra la actividad “Valencia cuida tu riñón”, con el fin de acercar la actividad del Laboratorio Clínico a la ciudadanía de la Comunidad Valenciana mediante el análisis en sangre de su función renal 🩸




🆕 Nace la Sociedad Española de Medicina de Laboratorio #SEMEDLAB @semedlab en #LABCLIN2024 🤝Fruto de la fusión entre las tres asociaciones científicas de Medicina de Laboratorio-Laboratorio Clínico actuales en España @aebmorg @aefa_es @SEQC_ML labclin2024.es/images/site/no…

¡Bienvenidos a la residencia! 🥼👋 📌 Desde la Comisión de Residentes y Jóvenes Especialistas de #SEMEDLAB dan algunos #tips para que los recién llegados R1 tengan una primera toma de contacto con nuestra especialidad ‼️

Roche transforma el diagnóstico por espectrometría de masas con el lanzamiento del cobas® Mass Spec #EuroMedLab2025 #Brussels #SEMEDLAB

Desentrañando el rol del Machine Learning en el Laboratorio Clínico. #EuroMedLab2025 #Brussels #SEMEDLAB



Dan comienzo los simposios del EuroMedLab 2025. Una gran oportunidad para que los profesionales de la Medicina de Laboratorio nos mantengamos actualizados en los nuevos avances. #EuroMedLab #Brussels #SEMEDLAB

📸 Imágenes de ponencias celebradas en el #EuroMedLab2025 1. Evaluating the ROMA test for Ovarian cancer 2. Colorectal cancer screening in the Netherlands 3. K+ measurement in NICU settings - risks and opportunities for improvement #SEMEDLAB #laboratorio



“No es autoinmune todo lo que reluce, ¿o sí?” En la I Jornada Interhospitalaria del Laboratorio Clínico hablaremos del papel de los anticuerpos en el diagnóstico de la EPID asociada a enfermedades autoinmunes. ¡Os esperamos! #SEMEDLAB #EPID @RrTechu @Semedlab…


📌Asamblea General Ordinaria Se ha habilitado una mesa electoral en el stand de la Sociedad #SEMEDLAB 👉Podrás emitir tu voto presencialmente entre las 10:30 y las 14:00 horas, y nuevamente entre las 15:00 y las 17:00 horas, previa identificación mediante DNI

Something went wrong.
Something went wrong.
United States Trends
- 1. Thanksgiving 415K posts
- 2. National Guard 83.6K posts
- 3. #InfoSecVPN N/A
- 4. Frank Ragnow 2,652 posts
- 5. Bayern 161K posts
- 6. Mbappe 84.3K posts
- 7. D.C. 212K posts
- 8. Arsenal 289K posts
- 9. Kimmich 5,267 posts
- 10. Patrick Morrisey 1,189 posts
- 11. Denzel 4,172 posts
- 12. Lennart Karl 5,701 posts
- 13. Olympiacos 19.5K posts
- 14. Anthony Rendon N/A
- 15. Golesh 3,119 posts
- 16. Wine 39.7K posts
- 17. Camp Haven 7,575 posts
- 18. Pizza 47.1K posts
- 19. #ARSBAY 4,001 posts
- 20. Fani Willis 23.1K posts









